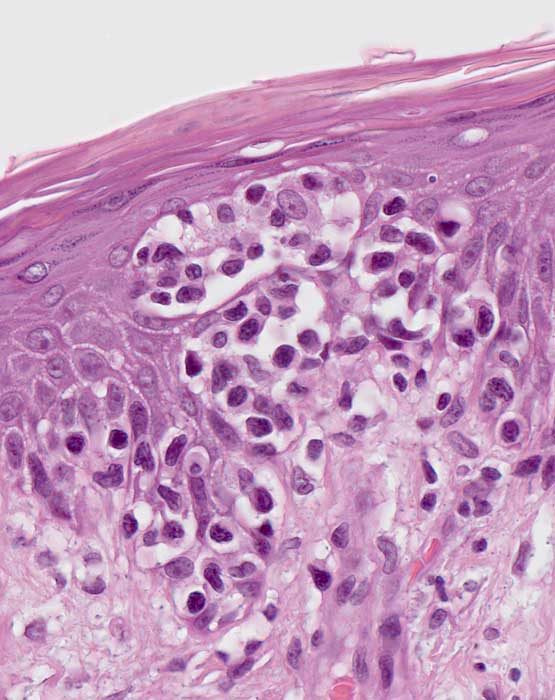

PathoPic – image database / PathoPic ID 6925 - Mycosis fungoides: Paultrier Mikroabszess
de
Diagnose
Mycosis fungoides: Paultrier Mikroabszess
Diagnose Gruppe
maligner Tumor
Topographie
Haut, untere Extremität
Topographie Gruppe
Haut
Beschreibung
Epidermotrophes Infiltrat atypischer, vergrösserter lymphoider Zellen in der Epidermis, teils in Form von Paultrier Mikroabszessen. Letztere bestehen aus atypischen Lymphozyten und Langerhanszellen mit grossen hellen Kernen und sternförmigen Zytoplasmaausläufern. Hyper-Orthokeratose und leichte Spongiose der Epidermis.
Klinik
Leicht erhabene scharf begrenzte Plaques mit feiner Schuppung an Rumpf und Oberschenkeln. Juckreiz.
Bilder Typ
Histologie
Vergrösserung
400
Alter
51
Geschlecht
männlich
Datum
Ersteintrag: 01.12.2003
Update: 15.12.2003